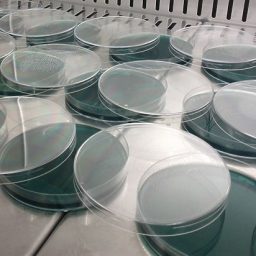

- +7
- 1
- Читать далее
- +16
- 10
- Читать далее
- +28
- 9
- Читать далее
- +22
- 5
- Читать далее
- +49
- 10
- Читать далее
- +37
- 8
- Читать далее
- +69
- 8
- Читать далее
- +20
- 6
- Читать далее
- +10
- 4
- Читать далее
- +29
- 9
- Читать далее
- +44
- 7
- Читать далее
- +70
- 10
- Читать далее
- +21
- Читать далее
- -6
- 5
- Читать далее
- +19
- 3
- Читать далее
- +6
- Читать далее
- +12
- Читать далее